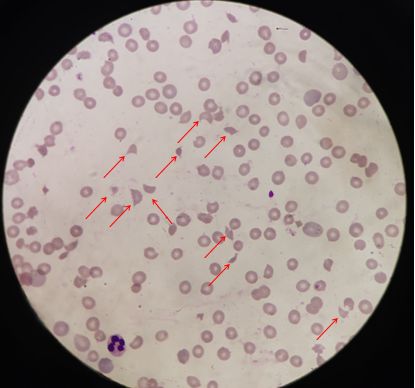

一例关于血涂片里有核红的案例

如果您碰到这样一份血常规结果,会怎么处理呢?会是什么病呢?

首先我们根据直观的结果来分析:1.中度贫血。2.血小板明显减低。3.仪器WNR散点图提示外周血出现有核红细胞,WDF散点图有幼稚粒细胞。4.血小板直方图异常。
处理方式:1.首先需要看一下血标本外观是否有凝集,以排除标本因素。2.如果标本外观正常,对于初诊病人出现这样的血常规结果,血涂片镜检是必须要做的。
镜检:发现大量的破碎红细胞。血栓性血小板减少性紫癜?您想到了吗?可能亲人之间的生离死别就在您的一张血涂片中。
我们来看一下病人的病史:男,71岁。
主诉:突发意识紊乱4天。
现病史:4天前凌晨无明显诱因突然出现意识紊乱,胡言乱语,行为异常,至当地医院就诊,完善相关检查后发现血小板减少,心肌酶异常,低钾血症,脑梗死。给予输机采血小板等对症治疗,效果不佳,,意识紊乱时轻时重,为求进一步治疗急诊送入我院。
既往史:否认“高血压、糖尿病、冠心病”等慢性病,否认“肝炎、结核”史,否认外伤史、过敏史。
查体:T36.5℃,P83次/分,R21次/分,BP140/80mmHg,发育正常,意识不清,全身皮肤、黏膜黄染,双上肢皮肤可见少量瘀斑,无肝掌、蜘蛛痣、皮疹,浅表淋巴结无肿大,其余未见明显异常。主管大夫也给出了血栓性血小板减少性紫癜的初步诊断。事不宜迟,我也及时联系了主管大夫,报告了血涂片结果,并询问了病人入院后的情况,得知由于病人病情延误时间过长,病情危重,家属放弃了治疗。
实验室检查:
生化项目:总胆红素145.5umol/L、直接胆红素23.9umol/L、间接胆红素121.6umol/L、尿素6.83mmol/L、肌酐86umol/L、尿酸261umol/L、二氧化碳22.9mmol/L、乳酸脱氢酶1573U/L;
凝血功能:PT10.9S、APTT26.4S、FIB384mg/dl、TT15.9S、D-二聚体920ng/ml、FDP4500ng/ml;
贫血三项:叶酸11.83ng/ml、维生素B12 476pg/ml、铁蛋白1196ng/ml;
自免17项:抗SSA/Ro60KD抗体、抗Ro52KD抗体、抗Jo-1抗体阳性,其余阴性;
后续相关的Coombs试验、ADAMTS-13活性及抑制物检查由于需联系第三方送检加之家属放弃治疗,最终也未能检查。不过,根据该病人典型的临床症状和已做检查结果来看也支持TTP诊断。
个人感想:虽然病人入院后临床大夫根据病人的病史、典型临床症状以及实验室及时的辅助检查使TTP的诊断基本明确。但是由于病人在当地耽误时间过久加之年龄过大,病情危重,最终家属放弃了抢救,自动出院。
如果我们基层检验人员遵循血常规复检规则,涂片镜检;如果看到了破碎红细胞;如果知道破碎红细胞和TTP的密切相关性,如果临床医生经验丰富,要求涂片查找破碎红细胞,如果病人能早来哪怕1天,可能就会有不同的结局。没有如果,只能亡羊补牢,未为迟也。总结TTP相关知识和大家共同学习。

定义:血栓性血小板减少性紫癜(TTP)是指因先天性或获得性血管性血友病因子(vWF)裂解蛋白酶ADAMTS-13活性缺乏导致的一类血栓性微血管病。
发病机制:由于TTP患者存在vWF裂解酶ADAMTS-13的活性缺乏,导致血浆中超大分子量vWF多聚体不能被有效降解,后者在高剪切力的作用下诱使血小板聚集进而导致微血管内富含血小板和vWF的血栓形成,全身微动脉和毛细血管均可受累。
临床表现:具有典型的“五联征”---发热、微血管病性溶血性贫血(MAHA)、血小板减少、肾功能损害和神经系统异常。事实上,仅有约5%的TTP患者具备所有的“五联征”,且出现“五联征”时常常代表疾病已进入晚期或危重阶段。因此并不利于患者的早期诊断。
分型:1.先天性TTP,由于ADAMTS-13基因突变导致酶活性降低或缺乏所致;2.获得性TTP,由于体内产生了针对ADAMTS-13的自身抗体(抑制物)而导致该酶活性降低或缺乏。根据有无明确基础疾病或诱发因素又分为原发性TTP和继发性TTP。临床上以原发性TTP最多见。
实验室检查:1.血小板减少:最为常见,常显著降低,半数以上患者降至20×109/L以下;2.微血管病性溶血性贫血:不同程度的贫血,伴网织红细胞增高;血清游离血红蛋白和间接胆红素升高,结合珠蛋白下降,乳酸脱氢酶明显升高。外周血涂片观察到破碎红细胞。原因是TTP形成的微血栓不完全堵塞微血管,造成红细胞在通过时受损形成破碎红细胞;3.凝血检查:APTT、PT及FIB检测多正常,偶有纤维蛋白降解产物轻度增高。4.血浆ADAMTS-13活性常<10%,或者同时检出ADAMTS-13抑制物。
诊断:由于TTP起病急骤,病情凶险,死亡率高,如能早期诊断并尽早给予血浆置换治疗,可以显著改善患者的预后。因此,目前TTP的诊断强调只要患者具有MAHA和血小板减少,且无其他病因可以解释,就应该高度怀疑TTP可能,并尽早开始血浆置换在内的治疗。对于疑诊的TTP患者应尽早行外周血涂片检查,发现破碎红细胞>1%是确定MAHA最直接和最重要的证据。确诊TTP需行ADAMTS-13活性及相应抑制物的测定。然而ADAMTS-13活性及抑制物检查目前来说在第三方检测机构开展较多,而大部分医院并未开展此项目,因此检查结果并不能及早获得,对于临床高度怀疑TTP的患者不应等结果回报,而应尽早开始血浆置换及免疫抑制治疗。
鉴别诊断:
治疗:血浆置换应尽早进行,可以显著降低死亡率。虽然TTP患者有严重的血小板减少,但是应避免血小板的输注,除非出现危及生命的严重出血时才考虑使用,因为输注血小板可能加剧TTP的病理生理学进展,造成更为严重的后果。
· 参考文献:
1.血液病诊断及疗效标准第4版[M]. 科学出版社 , 沈悌, 2018
2.阮长耿,余自强.2012版血栓性血小板减少性紫癜诊断与治疗中国专家共识解读[J].临床血液学杂志,2013,26(02):145-146.

